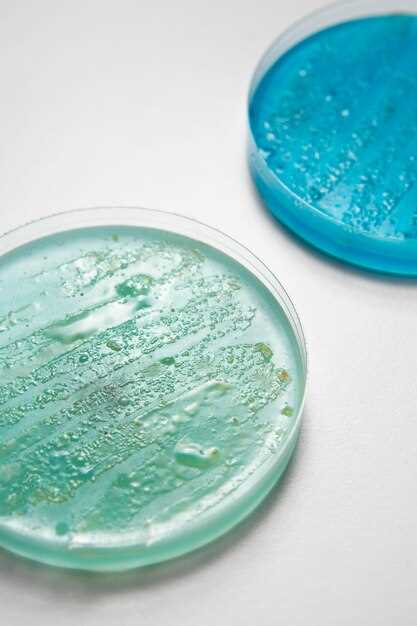
Sample Preparation

Solubility of escitalopram oxalate in water
2026-02-26Discover the exceptional solubility of escitalopram oxalate in water, providing a reliable solution for your pharmaceutical needs. With its high solubility profile, this compound ensures optimal dissolution and bioavailability for pharmaceutical formulations. Trust in the superior solubility properties of escitalopram oxalate and elevate your drug delivery systems to the next level.
Overview of Solubility Study
The solubility study of Escitalopram Oxalate in water is a crucial parameter in pharmaceutical research and development. It provides insights into the compound's ability to dissolve in aqueous media, which is essential for drug formulation and bioavailability. Solubility data helps determine the concentration of the drug that can be dissolved in a given volume of solvent under specific conditions. This information is valuable in optimizing drug delivery systems and designing dosage forms with enhanced efficacy and stability.
Overview of Solubility Study
The solubility study of Escitalopram Oxalate plays a crucial role in drug development and formulation. It involves determining the quantity of the compound that can dissolve in a given solvent under specific conditions.
Importance of Solubility Testing Methodology
The solubility testing methodology is essential for assessing the drug's bioavailability, stability, and formulation requirements. Various techniques such as shake-flask method, HPLC analysis, and UV spectroscopy are commonly used to determine the solubility of Escitalopram Oxalate.
| Method | Principle |
|---|---|
| Shake-Flask Method | Simple and cost-effective method to determine solubility. |
| HPLC Analysis | Highly sensitive method for quantifying the drug concentration in the solution. |
| UV Spectroscopy | Used to measure the absorbance of Escitalopram Oxalate at specific wavelengths. |
Overall, the solubility study provides valuable insights into the behavior of Escitalopram Oxalate in various formulations, aiding in the development of effective drug products.
Solubility Testing Methodology
Solubility testing methodology is crucial in determining the solubility of a substance in a specific solvent under defined conditions. This methodology involves various steps to accurately measure and quantify the solubility of the compound.
Sample Preparation
The first step in solubility testing methodology is the preparation of the sample. The compound of interest, in this case, escitalopram oxalate, is weighed accurately and added to the solvent in a controlled environment. The sample is then mixed thoroughly to ensure uniform distribution.
Equilibrium Determination
Once the sample is prepared, the system is allowed to reach equilibrium. This involves maintaining constant temperature and agitation to ensure that the compound has reached its maximum solubility in the solvent. Equilibrium is crucial for accurate solubility determination.
Overall, solubility testing methodology plays a vital role in understanding the behavior of compounds in various solvents, which is essential for pharmaceutical applications and formulation development.
Factors Affecting Solubility
In the context of solubility, several factors play a crucial role in determining the extent to which a substance dissolves in a solvent. Understanding these factors is essential for predicting and controlling the solubility of compounds. Some of the key factors influencing solubility include:
Nature of Solvent:
The nature of the solvent used can significantly impact the solubility of a compound. Polar solvents tend to dissolve polar compounds more effectively, while nonpolar solvents are better at dissolving nonpolar compounds.
Temperature:
Temperature has a significant influence on solubility. In general, the solubility of most solids increases with an increase in temperature, while the solubility of gases decreases with rising temperatures. However, this relationship may not hold true for all substances.
| Factor | Effect on Solubility |
|---|---|
| Polarity of Solvent | Affects solubility based on the compound's polarity |
| Temperature | Influences solubility of solids and gases differently |
Importance of Solubility Data
The solubility data of a compound, such as Escitalopram Oxalate, plays a crucial role in pharmaceutical research and development. Understanding the solubility of a drug is essential for formulating effective dosage forms, such as tablets, capsules, or injections.
Accurate solubility data helps in determining the dissolution rate of the drug, which is critical for ensuring the therapeutic efficacy and bioavailability of the medication. It also assists in predicting the stability and shelf-life of the drug product.
Moreover, solubility data is vital for establishing the optimal conditions for drug delivery, ensuring the drug is absorbed efficiently in the body. This information is essential for developing and optimizing the formulation of pharmaceutical products, ultimately improving patient compliance and treatment outcomes.
Applications in Pharmaceutical Industry
The solubility of escitalopram oxalate in water plays a crucial role in the pharmaceutical industry. By understanding the solubility profile of this compound, researchers and formulators can optimize the formulation of escitalopram oxalate-containing drug products for enhanced bioavailability and efficacy.
Drug Formulation
The solubility data of escitalopram oxalate can guide the selection of suitable excipients and formulation strategies to improve drug dissolution and absorption. This information is essential for developing oral tablets, capsules, and liquid dosage forms with the desired release profile and bioavailability.
Quality Control

Solubility testing is a critical parameter for quality control in the pharmaceutical industry. By monitoring the solubility of escitalopram oxalate during manufacturing processes, companies can ensure product consistency and compliance with regulatory standards.
- Optimizing drug formulations for improved bioavailability
- Ensuring product consistency and compliance with regulations
- Developing new drug delivery systems for enhanced therapeutic outcomes
